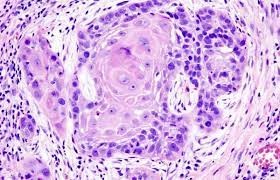
Hình ảnh ung thư dạ dày dưới kính hiển vi sau khi mẫu sinh thiết được xử lý

Sinh Thiết Mô Bệnh Học Bệnh Phẩm Dạ Dày
Sinh thiết dạ dày là gì? Là kĩ thuật mà bác sỹ nội soi sẽ dùng kìm bấm mẫu ở những vùng khác nhau ở tổn thương dạ dày làm xét nghiệm mô bệnh học và đọc dưới kính hiển vi.
Sinh thiết dạ dày thường được làm cùng lúc với nội soi dạ dày. Khi nội soi dạ dày thấy những tổn thương bất thường nghi ngờ bác sỹ sẽ lấy mẫu ở những vùng đấy gửi đi xét nghiệm thông qua ống nội soi được gắn camera. Việc hình ảnh từ camera được truyền trực tiếp lên màn hình bác sỹ sẽ quan sát được chính xác các vùng tổn thương từ đó có thể lấy mẫu chính xác.

Những lúc nào bệnh nhân nên đi nội soi dạ dày và thực hiện bấm mẫu sinh thiết:
Khi bệnh nhân có các triệu chứng sau:
+ Đau bụng vùng thượng vị.
+ Buồn nôn, nôn.
+ Mất cảm giác ngon miệng, ợ hơi ợ chua, cảm giác nóng rát vùng thượng vị.
+ Đi ngoài phân đen.
Khi bệnh nhân có những triệu chứng như trên cần đến bệnh viện để được bác sỹ thăm khám và nội soi dạ dày, trong quá trình soi nếu có tổn thương cần sinh thiết để xét nghiệm bác sỹ nội soi sẽ thực hiện sinh thiết ngay trong khi nội soi.
Những rủi ro có thể xảy ra khi thực hiện sinh thiết:
+ Chảy máu.
+ Thủng thực quản, dạ dày, trực tràng.
Ngay sau khi thực hiện sinh thiết bệnh phẩm sẻ được ngâm vào hóa chất bảo quản và gửi trực tiếp vào khoa Giải phẫu bệnh của bệnh viện đại học y dược Huế, và được trực tiếp các bác sỹ, kỹ thuật viên của bệnh viện thực hiện việc chẩn đoán.
Bệnh viện đa khoa hồng hà liên kết với các giáo sư đầu ngành về giải phẫu bệnh của bệnh viện y dược Huế. Mẫu gửi vào được trược tiếp PGS.TS: Đặng Công Thuận trưởng khoa giải phẫu bệnh, giảng viên cao cấp trường đại học y dược Huế và Th.s Ngô Cao Sách trực tiếp xử lý và đọc kết quả.
Hiện nay tại Bệnh viện đa khoa Hồng Hà đã triển khai kĩ thuật sinh thiết bệnh phẩm dạ dày qua nội soi, với đội ngũ bác sỹ, kĩ thuật viên có nhiều kinh nghiệm và trình độ chuyên môn cao, là địa chỉ uy tín trên địa bàn để bệnh nhân lựa chọn.
Hoàng Trọng Song

Một số bài viết khác:
Danh sách người thực hành khám bệnh, chữa bệnh tháng 12 năm 2025
LAN TỎA NIỀM TIN – GỬI TRỌN LỜI CẢM ƠN
HỘI THẢO KHOA HỌC CẬP NHẬT NHỮNG CÔNG NGHỆ MỚI TRONG CHẨN ĐOÁN HÌNH ẢNH
Chuyên gia Tim mạch hàng đầu BVTW Huế về Làm việc tại Hồng Hà
Nha khoa Hồng Hà tự hào đồng hành cùng Trường TH&THCS Thuận Lộc
HỒNG HÀ LAN TỎA YÊU THƯƠNG – TRAO TẶNG SỨC KHỎE CHO CỘNG ĐỒNG